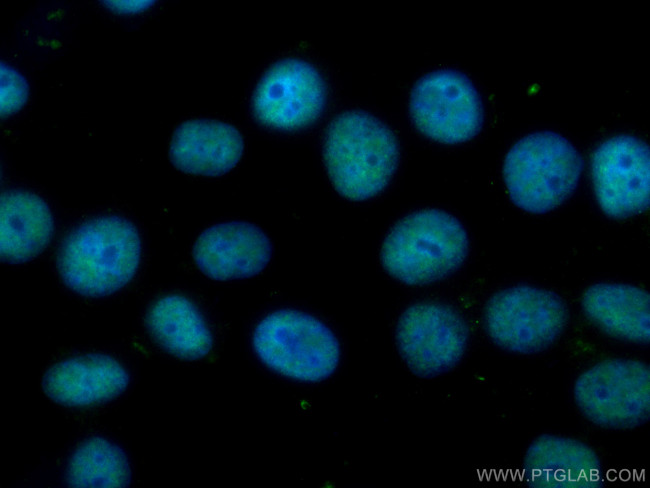
Cyclin H Antibody in Immunocytochemistry (ICC/IF)
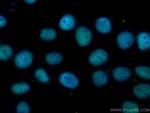
Cyclin H Antibody in Immunocytochemistry (ICC/IF)

Search
Proteintech
Cyclin H Monoclonal Antibody (2C5G11)
{{$productOrderCtrl.translations['antibody.pdp.commerceCard.promotion.promotions']}}
{{$productOrderCtrl.translations['antibody.pdp.commerceCard.promotion.viewpromo']}}
{{$productOrderCtrl.translations['antibody.pdp.commerceCard.promotion.promocode']}}: {{promo.promoCode}} {{promo.promoTitle}} {{promo.promoDescription}}. {{$productOrderCtrl.translations['antibody.pdp.commerceCard.promotion.learnmore']}}
产品信息
67065-1-IG
种属反应
宿主/亚型
分类
类型
克隆号
抗原
偶联物
形式
浓度
规格
纯化类型
保存液
内含物
保存条件
运输条件
产品详细信息
Aliquoting is unnecessary for -20°C storage.
靶标信息
The protein encoded by this gene belongs to the highly conserved cyclin family, whose members are characterized by a dramatic periodicity in protein abundance through the cell cycle. Cyclins function as regulators of CDK kinases. Different cyclins exhibit distinct expression and degradation patterns which contribute to the temporal coordination of each mitotic event. This cyclin forms a complex with CDK7 kinase and ring finger protein MAT1. The kinase complex is able to phosphorylate CDK2 and CDC2 kinases, thus functions as a CDK-activating kinase (CAK). This cyclin and its kinase partner are components of TFIIH, as well as RNA polymerase II protein complexes. They participate in two different transcriptional regulation processes, suggesting an important link between basal transcription control and the cell cycle machinery.
仅用于科研。不用于诊断过程。未经明确授权不得转售。
生物信息学
蛋白别名: CAK complex subunit; CCNH; CDK-activating kinase complex subunit; cyclin-dependent kinase-activating kinase complex subunit; Cyclin-H; MO15-associated protein; OTTHUMP00000222395; OTTHUMP00000222396; p34; p37; unnamed protein product
基因别名: 6330408H09Rik; AI661354; AV102684; AW538719; CAK; CCNH; CycH; p34; p37
UniProt ID: (Human) P51946, (Mouse) Q61458, (Rat) Q9R1A0
Entrez Gene ID: (Human) 902, (Mouse) 66671, (Rat) 84389